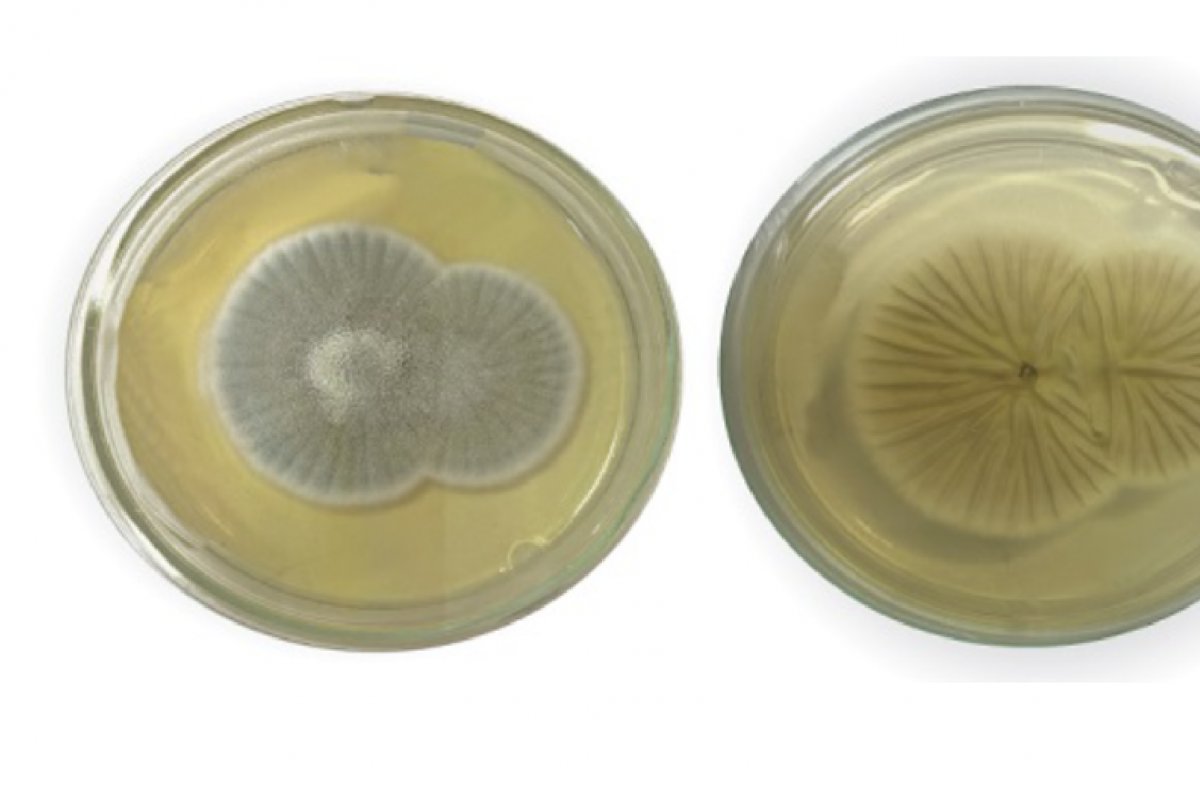
Primeiro caso de meningoencefalite por fungo 'Penicillium chrysogenum' é notificado no Brasil

Primeiro caso de meningoencefalite por fungo 'Penicillium chrysogenum' é notificado no Brasil
O microrganismo provocou infecção grave no cérebro e meninges de uma paciente do Rio de Janeiro
Foto: Reprodução
O primeiro caso no Brasil de meningoencefalite causada pelo fungo Penicillium chrysogenum, foi relatado em artigo liderado pelo Instituto Oswaldo Cruz (IOC/Fiocruz). O microrganismo provocou infecção grave no cérebro e meninges de uma paciente no município do Rio de Janeiro, levando-a a óbito.
O caso foi acompanhado no Hospital Naval Marcílio Dias, na Zona Norte da capital fluminense. Uma adolescente de 14 anos foi admitida no centro médico com dores de cabeça, fotofobia e vômito. De acordo com os exames, a jovem não apresentava comorbidades e aparentava possuir plena capacidade de reagir contra microrganismos patógenos.
A presença do fungo foi observada em análises do líquido cefalorraquidiano – substância que envolve o cérebro e a medula espinhal. As amostras foram enviadas para identificação taxonômica mais detalhada no Laboratório de Taxonomia, Bioquímica e Bioprospecção de Fungos do IOC.
A partir de metodologias fenotípicas, que envolvem a caracterização taxonômica, e técnicas moleculares, foi confirmado que o fungo encontrado pertencia à espécie Penicillium chrysogenum.
Com a confirmação, os médicos do Marcílio Dias iniciaram tratamento da jovem com duas classes de medicamentos antifúngicos. Apesar dos esforços, a paciente veio a óbito em decorrência de choque séptico e neurogênico.
A forma como a paciente foi infectada pelo P. chrysogenum não ficou evidente. Embora o fungo esteja amplamente distribuindo no ambiente, é mais comum encontra-lo em solos onde há matéria em decomposição, passagem de esgotos e obras.


